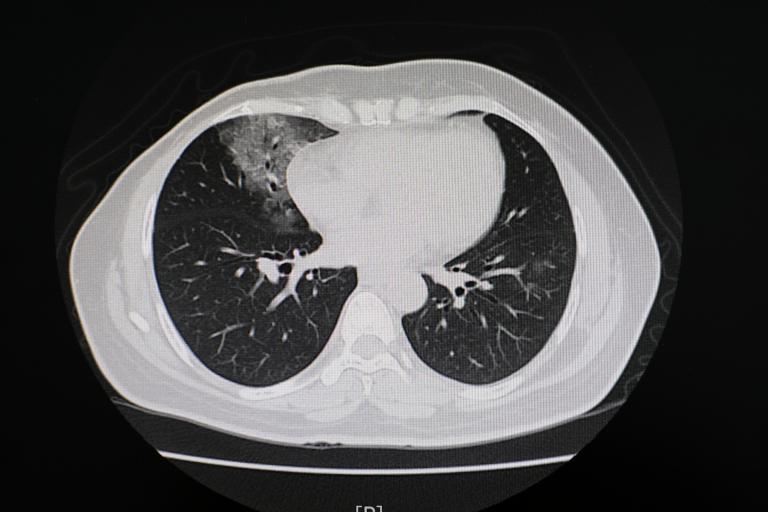
An image of a medical chest scan is shown.

All News
Effective Jan. 31, 2026, Gary H. Gibbons, M.D., director of the National Heart, Lung, and Blood Institute (NHLBI) at the National Institutes of Health (NIH), is retiring from federal service.
Effective Jan. 31, 2026, Gary H. Gibbons, M.D., director of the National Heart, Lung, and Blood Institute (NHLBI) at the National Institutes of Health (NIH), is retiring from federal service.
This indicator improved predictions for major heart problems among adults with limited blood flow to their heart.
An observational study with more than 40,000 adults found that morning coffee drinkers had a 16% reduced associated risk of dying from any cause throughout nearly 10 years compared to non-coffee drinkers.